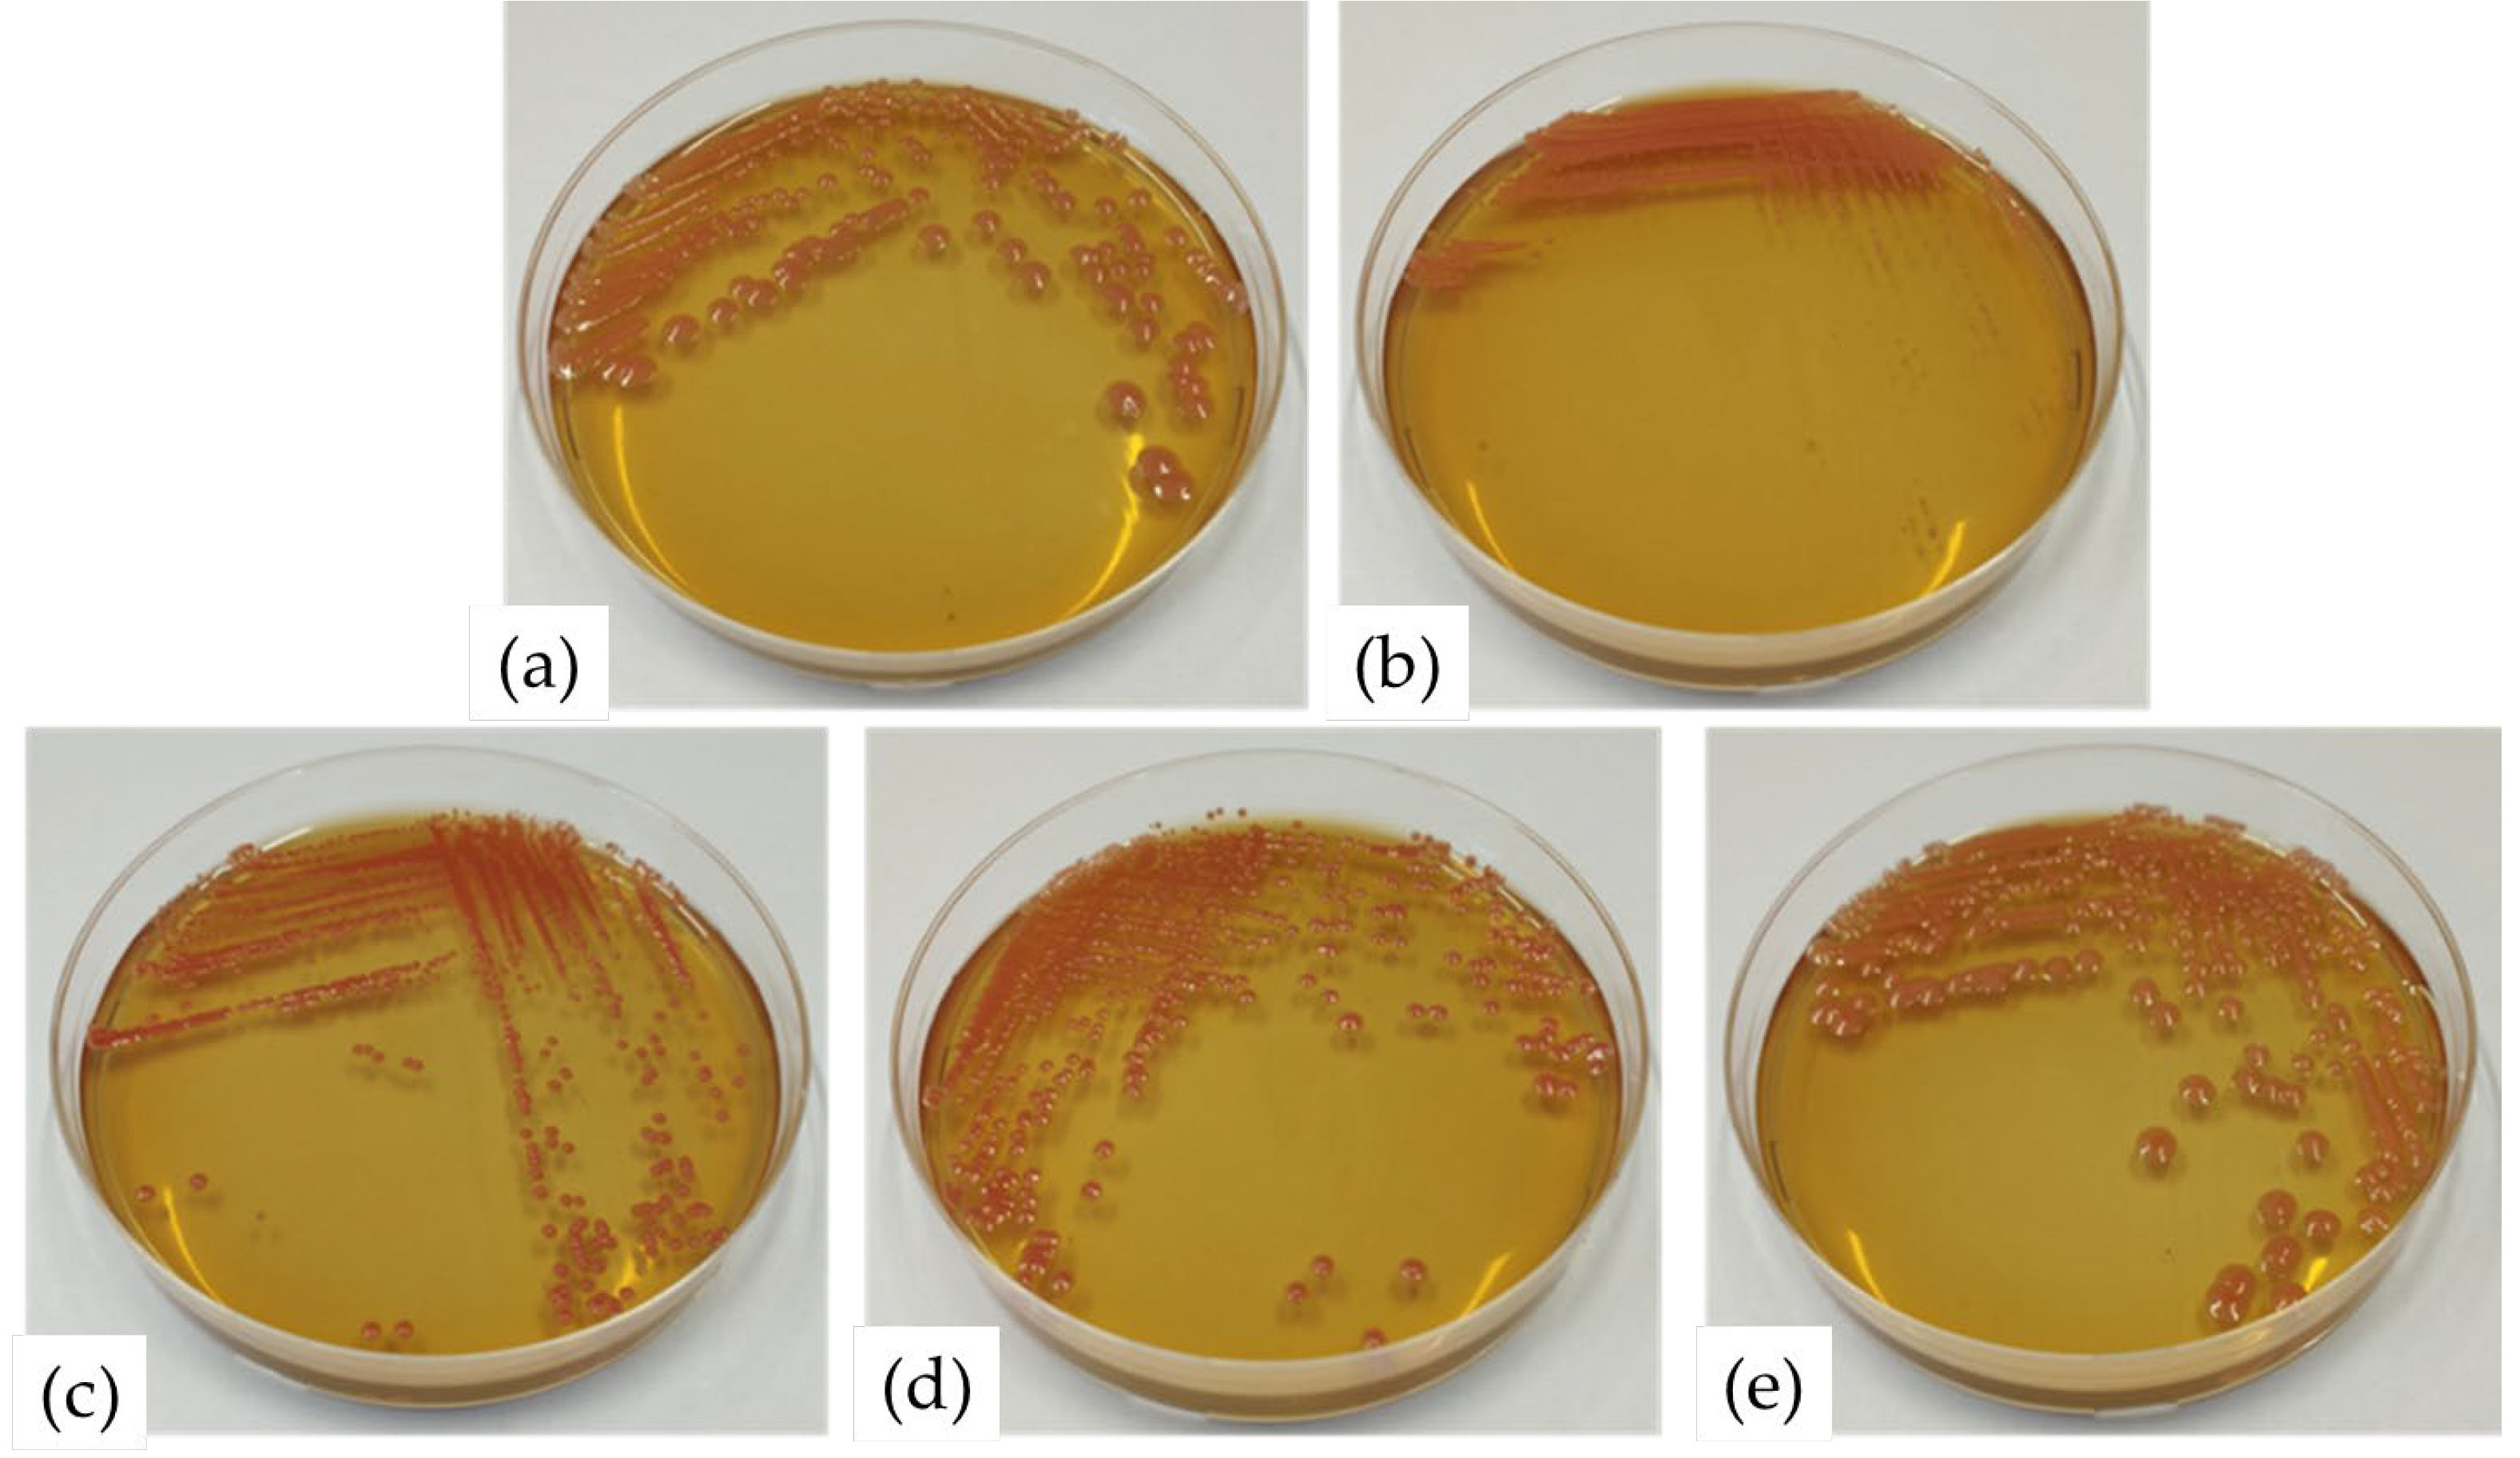

Carotenoid-Producing Yeasts: Selection of the Best-Performing Strain and the Total Carotenoid Extraction Procedure
Abstract
1. Introduction
2. Materials and Methods
2.1. Yeast Isolates and Their Characteristics
2.2. Biomass Production
2.3. Experimental Design for Extraction of Total Carotenoids from Yeast Cells
- Methods for cell lysis: chemical (hydrochloric acid treatment and sodium chloride treatment) and mechanical (ultrasound wave treatment and milling) methods;
- Carotenoid extraction methods: conventional extraction (CE), ultrasound extraction (USE), and a combination of conventional and ultrasound extraction (CUSE); and
- Solvent extraction methods: acetone, isopropanol: methanol (50:50), and ethanol extraction.
2.4. Methods for Cell Lysis
2.5. Methods for Carotenoid Extraction
2.6. Statistical Analysis
2.6.1. Growth Kinetics Modelling
2.6.2. Cluster Analysis of Temperature and pH Growth Profiles of Yeast Isolates
2.6.3. Ranking Procedure
2.6.4. Artificial Neural Network (ANN) Optimization
2.7. Experimental Validation of the Universality of the Chosen Carotenoid Extraction Procedure
3. Results and Discussion
- Cell lysis methods (hydrochloric acid treatment, ultrasound treatment, milling treatment, and osmotic pressure treatment);
- Extraction methods (conventional extraction, ultrasound extraction, conventional + ultrasound extraction); and
- Solvent extraction methods (acetone, isopropanol/methanol (50:50), and ethanol extraction).
| Yeast Isolate | χ2 | RMSE | MBE | MPE | r2 |
|---|---|---|---|---|---|
| R. mucilaginosa top 30 | 3.1 × 104 | 17.49 | −13.27 | 14.29 | 0.89 |
| Skew | Kurt | Mean | StDev | Var | |
| 2.22 | 11.62 | −13.27 | 17.68 | 3.1 × 104 |
4. Conclusions
Supplementary Materials
Author Contributions
Funding
Institutional Review Board Statement
Informed Consent Statement
Data Availability Statement
Conflicts of Interest
References
- Cheng, Y.-T.; Yang, C.-F. Using strain Rhodotorula mucilaginosa to produce carotenoids using food wastes. J. Taiwan Inst. Chem. Eng. 2016, 61, 270–275. [Google Scholar] [CrossRef]
- Mannazzu, I.; Landolfo, S.; da Silva, T.L.; Buzzini, P. Red yeasts and carotenoid production: Outlining a future for non-conventional yeasts of biotechnological interest. World J. Microbiol. Biotechnol. 2015, 31, 1665–1673. [Google Scholar] [CrossRef]
- Kultys, E.; Kurek, M.A. Green Extraction of Carotenoids from Fruit and Vegetable Byproducts: A Review. Molecules 2022, 27, 518. [Google Scholar] [CrossRef] [PubMed]
- Saini, R.K.; Keum, Y.-S. Carotenoid extraction methods: A review of recent developments. Food Chem. 2018, 240, 90–103. [Google Scholar] [CrossRef] [PubMed]
- Pisoschi, A.M.; Pop, A.; Cimpeanu, C.; Predoi, G. Antioxidant capacity determination in plants and plant-derived products: A review. Oxidative Med. Cell. Longev. 2016, 2016, 9130976. [Google Scholar] [CrossRef] [PubMed]
- Cikoš, A.M.; Jokić, S.; Šubarić, D.; Jerković, I. Overview on the application of modern methods for the extraction of bioactive compounds from marine macroalgae. Mar. Drugs 2018, 16, 348. [Google Scholar] [CrossRef]
- Mussagy, C.U.; Winterburn, J.; Santos-Ebinuma, V.C.; Pereira, J. Production and extraction of carotenoids produced by microorganisms. Appl. Microbiol. Biotechnol. 2018, 103, 1095–1114. [Google Scholar] [CrossRef]
- Zhao, Y.; Guo, L.; Xia, Y.; Zhuang, X.; Chu, W. Isolation, Identification of Carotenoid-Producing Rhodotorula sp. from Marine Environment and Optimization for Carotenoid Production. Mar. Drugs 2019, 17, 161. [Google Scholar] [CrossRef]
- Igreja, W.S.; Maia, F.A.; Lopes, A.S.; Chisté, R.C. Biotechnological Production of Carotenoids Using Low Cost-Substrates is Influenced by Cultivation Parameters: A Review. Int. J. Mol. Sci. 2021, 22, 8819. [Google Scholar] [CrossRef]
- Willemsen, M.; Breynaert, J.; Lauwers, S. Comparison of Auxacolor with API 20 C Aux in yeast identification. Clin. Microbiol. Infect. 1997, 3, 369–375. [Google Scholar] [CrossRef][Green Version]
- Mateo, J.J.; Garcerà, P.; Maicas, S. Unusual Non-Saccharomyces Yeasts Isolated from Unripened Grapes without Antifungal Treatments. Fermentation 2020, 6, 41. [Google Scholar] [CrossRef]
- Arastehfar, A.; Daneshnia, F.; Kord, M.; Roudbary, M.; Zarrinfar, H.; Fang, W.; Hashemi, S.J.; Najafzadeh, M.J.; Khodavaisy, S.; Pan, W.; et al. Comparison of 21-Plex PCR and API 20C AUX, MALDI-TOF MS, and rDNA Sequencing for a Wide Range of Clinically Isolated Yeast Species: Improved Identification by Combining 21-Plex PCR and API 20C AUX as an Alternative Strategy for Developing Countries. Front. Cell. Infect. Microbiol. 2019, 9, 21. [Google Scholar] [CrossRef]
- Šovljanski, O.; Tomić, A.; Pezo, L.; Markov, S. Temperature and pH growth profile prediction of newly isolated bacterial strains from alkaline soils. J. Sci. Food Agric. 2019, 100, 1155–1163. [Google Scholar] [CrossRef]
- González-García, Y.; Rábago-Panduro, L.M.; French, T.; Camacho-Córdova, D.I.; Gutiérrez-González, P.; Córdova, J. High lipids accumulation in Rhodosporidium toruloides by applying single and multiple nutrients limitation in a simple chemically defined medium. Ann. Microbiol. 2019, 67, 519–527. [Google Scholar] [CrossRef]
- De Bonadio, M.P.; De Freita, L.A.; Mutton, M.J.R. Carotenoid production in sugarcane juice and synthetic media supplemented with nutrients by Rhodotorula rubra l02. Braz. J. Microbiol. 2018, 394, 7. [Google Scholar] [CrossRef]
- Kot, A.M.; Błażejak, S.; Kieliszek, M.; Gientka, I.; Bryś, J. Simultaneous Production of Lipids and Carotenoids by the Red Yeast Rhodotorula from Waste Glycerol Fraction and Potato Wastewater. Appl. Biochem. Biotechnol. 2019, 189, 589–607. [Google Scholar] [CrossRef]
- Hien Ly, T.M.; Nga Pham, T.H. Effects of some factors on carotenoid biosynthesis by Rhodotorula Mucilaginosa. Ho Chi Minh City Open Univ. J. Sci. 2019, 9, 62–69. [Google Scholar]
- Rovinaru, C.; Pasarin, D.; Capra, L.; Stoica, R. The effect of ZnSO4 in the cultivation medium of Rhodotorula glutinis CCY 020-002-033 yeast biomass growth, β-carotene production and zinc accumulation. J. Microbiol. Biotechnol. Food Sci. 2019, 8, 931–935. [Google Scholar] [CrossRef]
- Jeliński, T.; Przybyłek, M.; Cysewski, P. Natural deep eutectic solvents as agents for improving solubility, stability and delivery of curcumin. Pharm. Res. 2019, 36, 116. [Google Scholar] [CrossRef]
- Mata-Gómez, L.C.; Montañez, J.C.; Méndez-Zavala, A.; Aguilar, C.N. Biotechnological production of carotenoids by yeasts: An overview. Microb. Cell Fact. 2014, 13, 12. [Google Scholar] [CrossRef]
- Lopes, N.A.; Remedi, R.D.; Dos Santos Sá, C.; Burkert, C.A.V.; de Medeiros Burkert, J.F. Different cell disruption methods for obtaining carotenoids by Sporodiobolus pararoseus and Rhodothorula mucilaginosa. Food Sci. Biotechnol. 2017, 26, 759–766. [Google Scholar] [CrossRef]
- Michelon, M.; de Matos de Borba, T.; da Silva Rafael, R.; Burkert, C.A.V.; de Medeiros Burkert, J.F. Extraction of carotenoids from Phaffia rhodozyma: A comparison between different techniques of cell disruption. Food Sci. Biotechnol. 2012, 21, 1–8. [Google Scholar] [CrossRef]
- Nemer, G.; Louka, N.; Vorobiev, E.; Salameh, D.; Nicaud, J.-M.; Maroun, R.G.; Koubaa, M. Mechanical Cell Disruption Technologies for the Extraction of Dyes and Pigments from Microorganisms: A Review. Fermentation 2021, 7, 36. [Google Scholar] [CrossRef]
- Brlek, T.; Pezo, L.; Voća, N.; Krička, T.; Vukmirović, Đ.; Čolović, R.; Bodroža-Solarov, M. Chemometric approach for assessing the quality of olive cake pellets. Fuel Process. Technol. 2013, 116, 250–256. [Google Scholar] [CrossRef]
- Momenzadeh, L.; Zomorodian, A.; Mowla, D. Experimental and theoretical investigation of shelled corn drying in a microwave-assisted fluidized bed dryer using Artificial Neural Network. Food Bioprod. Process. 2011, 89, 15–21. [Google Scholar] [CrossRef]
- Trelea, I.C.; Raoult-Wack, A.L.; Trystram, G. Note: Application of neural network modelling for the control of dewatering and impregnation soaking process (osmotic dehydration). Food Sci. Technol. Int. 1997, 3, 459–465. [Google Scholar] [CrossRef]
- Šovljanski, O.; Pezo, L.; Tomić, A.; Ranitović, A.; Cvetković, D.; Markov, S. Contribution of bacterial cells as nucleation centers in microbiologically induced CaCO3 precipitation—A mathematical modeling approach. J. Basic Microbiol. 2021, 61, 835–848. [Google Scholar] [CrossRef] [PubMed]
- Basheer, I.A.; Hajmeer, M. Artificial neural networks: Fundamentals, computing, design, and application. J. Microbiol. Methods 2000, 43, 3–31. [Google Scholar] [CrossRef]
- Otero, D.M.; Bulsing, B.A.; da Huerta, K.M.; Rosa, C.A.; Zambiazi, R.C.; Burkert, C.A.V.; de Burkert, J.F.M. Carotenoid-producing yeasts in the Brazilian biodiversity: Isolation, identification and cultivation in agroindustrial waste. Braz. J. Chem. Eng. 2019, 36, 117–129. [Google Scholar] [CrossRef]
- Bhosale, P.; Gadre, R.V. Optimization of carotenoid production from hyper-producing Rhodotorula glutinis mutant 32 by a factorial approach. Lett. Appl. Microbiol. 2001, 33, 12–16. [Google Scholar] [CrossRef]
- Kot, A.M.; Błażejak, S.; Kurcz, A.; Gientka, I.; Kieliszek, M. Rhodotorula glutinis—potential source of lipids, carotenoids, and enzymes for use in industries. Appl. Microbiol. Biotechnol. 2016, 100, 6103–6117. [Google Scholar] [CrossRef] [PubMed]
- Keceli, T.M.; Erginkaya, Z.; Turkkan, E.; Kaya, U. Antioxidant and Antibacterial Effects of Carotenoids Extracted from Rhodotorula glutinis Strains. Asian J. Chem. 2013, 25, 42–46. [Google Scholar] [CrossRef]
- Wirth, F.; Goldani, L.Z. Epidemiology of Rhodotorula: An Emerging Pathogen. Interdiscip. Perspect. Infect. Dis. 2012, 2012, 465717. [Google Scholar] [CrossRef]
- Dyaa, A.; Soliman, H.; Abdelrazak, A.; Samra, B.N.; Khojah, E.; Ahmed, A.F.; El-Esawi, M.A.; Elsayed, A. Optimization of Carotenoids Production from Rhodotorula sp. Strain ATL72 for Enhancing its Biotechnological Applications. J. Fungi 2022, 8, 160. [Google Scholar] [CrossRef]
- Rosso, L.; Lobry, J.R.; Bajard, S.; Flandrois, J.P. Convenient Model to Describe the Combined Effects of Temperature and pH on Microbial Growth. Appl. Environ. Microbiol. 1995, 61, 610–616. [Google Scholar] [CrossRef]
- Endeshaw, A.; Birhanu, G.; Zerihun, T.; Misganaw, W. Application of microorganisms in bioremediation-review. J. Environ. Microbiol. 2017, 1, 2–9. [Google Scholar]
- Liu, X.; Jia, B.; Sun, X.; Ai, J.; Wang, L.; Wang, C.; Huang, W. Effect of Initial PH on Growth Characteristics and Fermentation Properties of Saccharomyces cerevisiae. J. Food Sci. 2015, 80, M800–M808. [Google Scholar] [CrossRef]
- Wang, Q.; Liu, D.; Yang, Q.; Wang, P. Enhancing carotenoid production in Rhodotorula mucilaginosa KC8 by combining mutation and metabolic engineering. Ann. Microbiol. 2017, 67, 425–431. [Google Scholar] [CrossRef]
- Urano, N.; Shirao, A.; Naito, Y.; Okai1, M.; Ishida, M.; Takashio, M. Molecular Phylogeny and Phenotypic Characterization of Yeasts with a Broad Range of pH Tolerance Isolated from Natural Aquatic Environments. Adv. Microbiol. 2019, 9, 56–73. [Google Scholar] [CrossRef]
- Tinoi, J.; Rakariyatham, N.; Deming, R.L. Simplex optimization of carotenoid production by Rhodotorula glutinis using hydrolyzed mung bean waste flour as substrate. Process. Biochem. 2005, 40, 2551–2557. [Google Scholar] [CrossRef]
- Ishmayana, S.; Kennedy, U.J. Preliminary Evidence of Inositol Supplementation Effect on Cell Growth, Viability and Plasma Membrane Fluidity of the Yeast Saccharomyces cerevisiae. Procedia Chem. 2015, 17, 162–169. [Google Scholar] [CrossRef][Green Version]
- Allahkarami, S.; Akhavan Sepahi, A. Isolation and identification of carotenoid-producing Rhodotorula sp. from Pinaceae forest ecosystems and optimization of in vitro carotenoid production. Biotechnol. Rep. 2021, 32, e00687. [Google Scholar] [CrossRef]
- Moreira, F.G.; Lenartovicz, V. The use of α-methyl-D-glucoside, a synthetic analogue of maltose, as inducer of amylase by Aspergillus sp. in soild-state and submerged fermentations. Braz. J. Microbiol. 2001, 32, 15–19. [Google Scholar] [CrossRef]
- Nascimento, V.M.; Antoniolli, G.T.U.; Leite, R.S.R.; Fonseca, G.G. Effects of the carbon source on the physiology and invertase activity of the yeast Saccharomyces cerevisiae FT858. 3 Biotech 2020, 10, 348. [Google Scholar] [CrossRef]
- Becerra, M.; Belmonte, E.R.; Cerdán, M.E.; Siso, M.I.G. Extraction of intra cell proteins from Kluyveromyces lactis. Food Technol. Biotechnol. 2001, 39, 135–139. [Google Scholar]
- Buxadó, J.A.; Heynngnezz, L.E.; Juiz, A.G.; Tamayo, G.; Lima, I.R.; Marshalleck, H.D.; Mola, E.L. Scale-up of processes to isolate the misstargeted rBm86 protein from Pichia pastoris. Afr. J. Biotechnol. 2004, 11, 599–605. [Google Scholar]
- Kula, M.; Schütte, H.; Vogels, G.; Frank, A. Cell disintegration for the purification of intracellular proteins. Food Biotechnol. 1990, 4, 169–183. [Google Scholar] [CrossRef]
- Liu, D.; Ding, L.; Sun, J.; Boussetta, N.; Vorobiev, E. Yeast cell disruption strategies for recovery of intracellular bio-active compounds—A review. Innov. Food Sci. Emerg. Technol. 2016, 36, 181–192. [Google Scholar] [CrossRef]
- Desai, K.M.; Survase, S.A.; Saudagar, P.S.; Lele, S.S.; Singhal, R.S. Comparison of artificial neural network (ANN) and response surface methodology (RSM) in fermentation media optimization: Case study of fermentative production of scleroglucan. Biochem. Eng. J. 2008, 41, 266–273. [Google Scholar] [CrossRef]
- Aksu, Z.; Eren, A.T. Carotenoids production by the yeast Rhodotorula mucilaginosa: Use of agricultural wastes as a carbon source. Process Biochem. 2005, 40, 2985–2991. [Google Scholar] [CrossRef]
- D’Evoli, L.; Lombardi-Boccia, G. Influence of Heat Treatments on Carotenoid Content of Cherry Tomatoes. Foods 2013, 2, 352–363. [Google Scholar] [CrossRef] [PubMed]
- Joshi, C.; Singhal, R.S. Modelling and optimization of zeaxanthin production by Paracoccus zeaxanthinifaciens ATCC 21588 using hybrid genetic algorithm techniques. Biocatal. Agric. Biotechnol. 2016, 8, 228–235. [Google Scholar] [CrossRef]
- Montgomery, D.C. Design and Analysis of Experiments; John Wiley and Sons Ltd.: Hoboken, NJ, USA, 1984. [Google Scholar]
- Madamba, P.S. The Response Surface Methodology: An Application to Optimize Dehydration Operations of Selected Agricultural Crops. LWT 2002, 35, 584–592. [Google Scholar] [CrossRef]
- Shafi, J.; Sun, Z.; Ji, M.; Gu, Z.; Ahmad, W. ANN and RSM based modelling for optimization of cell dry mass of Bacillus sp. strain B67 and its antifungal activity against Botrytis cinerea. Biotechnol. Biotechnol. Equip. 2017, 32, 58–68. [Google Scholar] [CrossRef]
- Popescu, M.; Iancu, P.; Pleșu, V.; Sorin, C.; Todasca, C.M. Different spectrophotometric methods for simultaneous quantification of lycopene and β-carotene from a binary mixture. LWT 2022, 160, 113238. [Google Scholar] [CrossRef]

| Regression Coefficient | Yeast Isolate | ||||
|---|---|---|---|---|---|
| Top 30 | KV1105 | CRV | 4_34 | FK3 | |
| d | 7.977 | 7.059 | 7.421 | 8.152 | 6.393 |
| a | 3.872 | 3.670 | 3.525 | 3.698 | 4.021 |
| c | 43.335 | 38.766 | 35.446 | 73.525 | 46.521 |
| b | 2.829 | 2.654 | 1.571 | 5.041 | 3.016 |
| Parameter | Yeast Isolate | ||||
|---|---|---|---|---|---|
| Top 30 | KV1105 | CRV | 4_34 | FK3 | |
| Reduced chi-square (χ2) | 0.362 | 0.135 | 0.017 | 0.060 | 0.406 |
| Root mean square error (RMSE) | 0.578 | 0.353 | 0.124 | 0.235 | 0.612 |
| Mean bias error (MBE) | 0.000 | 0.000 | 0.000 | 0.000 | 0.000 |
| Mean percentage error (MPE) | 7.551 | 4.586 | 1.791 | 3.099 | 8.242 |
| Coefficient of determination (r2) | 0.872 | 0.922 | 0.989 | 0.985 | 0.680 |
| Skewness (Skew) | −0.382 | −1.127 | −0.863 | −1.296 | −2.090 |
| Kurtosis (Kurt) | −0.712 | 1.240 | 0.514 | 2.523 | 5.373 |
| Mean of residuals (Mean) | 0.000 | 0.000 | 0.000 | 0.000 | 0.000 |
| Standard deviation of residuals (StDev) | 0.601 | 0.368 | 0.129 | 0.245 | 0.637 |
| Variance of residuals (Var) | 0.362 | 0.135 | 0.017 | 0.060 | 0.406 |
| Yeast Isolate | Sum of Utilization Scores | Sum of Production Scores | Total Sum of Scores | Number of Positive Reactions | Number of Negative Reactions |
|---|---|---|---|---|---|
| top 30 | 10 | 3 | 13 | 13 | 9 |
| KV1105 | 4 | 1 | 5 | 5 | 17 |
| CRV | 6 | 1 | 7 | 7 | 15 |
| 4_34 | 9 | 2 | 11 | 11 | 11 |
| FK3 | 11 | 1 | 12 | 12 | 10 |
Publisher’s Note: MDPI stays neutral with regard to jurisdictional claims in published maps and institutional affiliations. |
© 2022 by the authors. Licensee MDPI, Basel, Switzerland. This article is an open access article distributed under the terms and conditions of the Creative Commons Attribution (CC BY) license (https://creativecommons.org/licenses/by/4.0/).
Share and Cite
Šovljanski, O.; Saveljić, A.; Tomić, A.; Šeregelj, V.; Lončar, B.; Cvetković, D.; Ranitović, A.; Pezo, L.; Ćetković, G.; Markov, S.; et al. Carotenoid-Producing Yeasts: Selection of the Best-Performing Strain and the Total Carotenoid Extraction Procedure. Processes 2022, 10, 1699. https://doi.org/10.3390/pr10091699
Šovljanski O, Saveljić A, Tomić A, Šeregelj V, Lončar B, Cvetković D, Ranitović A, Pezo L, Ćetković G, Markov S, et al. Carotenoid-Producing Yeasts: Selection of the Best-Performing Strain and the Total Carotenoid Extraction Procedure. Processes. 2022; 10(9):1699. https://doi.org/10.3390/pr10091699
Chicago/Turabian StyleŠovljanski, Olja, Anja Saveljić, Ana Tomić, Vanja Šeregelj, Biljana Lončar, Dragoljub Cvetković, Aleksandra Ranitović, Lato Pezo, Gordana Ćetković, Siniša Markov, and et al. 2022. "Carotenoid-Producing Yeasts: Selection of the Best-Performing Strain and the Total Carotenoid Extraction Procedure" Processes 10, no. 9: 1699. https://doi.org/10.3390/pr10091699
APA StyleŠovljanski, O., Saveljić, A., Tomić, A., Šeregelj, V., Lončar, B., Cvetković, D., Ranitović, A., Pezo, L., Ćetković, G., Markov, S., & Čanadanović-Brunet, J. (2022). Carotenoid-Producing Yeasts: Selection of the Best-Performing Strain and the Total Carotenoid Extraction Procedure. Processes, 10(9), 1699. https://doi.org/10.3390/pr10091699

